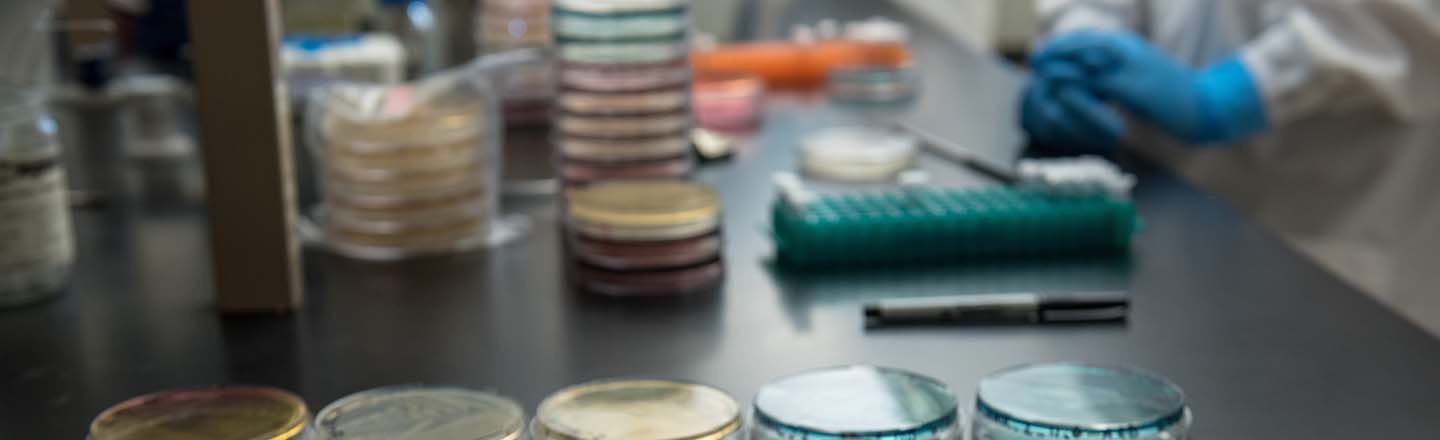
Close up of petri dishes with person in background wearing safety gear.

What is Public Health?
Public health is the science of protecting and improving the health of people and their communities.窶ッ
It involves promoting healthy lifestyles, preventing disease and injuries and addressing systemic factors that contribute to health disparities.
Public health professionals have a strong social justice focus aimed at promoting equity and reducing health disparities.
As a public health professional, you can work at the community or population level and can make an impact locally and globally.
ヘ荿ャテナ offers you several options for a career in public health.
Explore ヘ荿ャテナ's Public Health Programs
What Can I Do with a Public Health Degree?
Public health professionals work for government agencies, health care providers, NGOs and more.
Areas of Public Health Study:
- Epidemology
- Biostatistics
- Health Policy
- Environmental Health
- Social and Behavioral Sciences
- Health communication
Top Employers in Public Health:
- Center for Disease Control and Prevention (CDC)
- Public Health Departments
- National Institutes of Health (NIH)
- Academia
- Hospitals and Medical Facilities
- Managed Care Organizations
- Corporations
- Nonprofits
What You Will Learn in a Public Health Program
ヘ荿ャテナ's public health programs offer valuable in-demand skills.
- Communication - health literacy, persuasive communication, cultural sensitivity and communication strategy.
- Writing窶ッ- critical thinking, grant writing, conducting needs assessments and program evaluation.
- Research - data analysis, statistical methods and biostatistics.
- Project Organization and Management窶ッ- social marketing, program design, program implementation and targeted health programming.
Why Choose ヘ荿ャテナ for Public Health?
We are committed to the pursuit of knowledge and promotion of the greater good.
- Inspired by the Jesuit tradition of academic excellence and service to others, the Public Health Department at ヘ荿ャテナ University is grounded in the values of health equity, compassion, social justice, and the inherent dignity of every individual. Our mission is to advance public health through education, service, and community engagement. We seek to expand public health knowledge and contribute to evidence-based solutions that improve the health and quality of life for communities locally, nationally, and globally.
We strive to create leaders who are dedicated to the well-being of diverse populations.
- Our faculty and staff are committed to fostering an inclusive and collaborative learning environment that prepares students to address the most pressing public health challenges of our time.
We empower students to make a positive impact on public health and create a more just and healthy world.
- As an integral part of the School of Health Science and the broader ヘ荿ャテナ University community, the Public Health Department is dedicated to nurturing the mind, body and spirit of all individuals.
Department Questions?
Contact: Robin Pickering, Ph.D.
Professor and Chair, Public Health
(509) 313-5989
pickering@gonzaga.edu